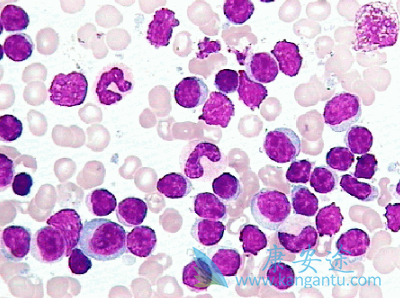
³

粒细胞集落刺激因子(G-CSF)是一种重要的造血生长因子,能控制中性粒细胞的产生。G-CSFR的突变会导致多种血液障碍,然而经过多年的研究,G-CSFR突变如何导致疾病发生的分子机制依然不清楚。近日,研究表明BTK作为G-CSFR突变下游一个潜在的治疗靶点,突变导致布鲁顿酪氨酸激酶BTK持续激活,BTK抑制剂依鲁替尼(IBRUTINIB)可用于治疗携G-CSFR突变的髓样白血病患者。
磷酸化组学分析揭示Btk异常激活进一步地激酶富集分析发现突变体中BTK活性显著改变。令人惊喜的是,如今Btk已经能作为药物依鲁替尼(IBRUTINIB)的作用靶点,用来治疗B细胞淋巴瘤或淋巴细胞白血病。因此作者选取BTK进一步研究其能否作为突变型G-CSFR下游的潜在治疗靶点。髓系模型验证BTK激活与突变的相关性作者选取骨髓祖细胞系32D细胞建立G-CSFR野生型和突变体模型,检测BKT抑制剂依鲁替尼干预后细胞增殖情况。结果表明相比正常的细胞,突变体中BTK异常激活表达,在使用依鲁替尼干预后,BTK表达被抑制,从而抑制细胞的增殖。
这些发现表明,依鲁替尼(IBRUTINIB)可以靶向治疗临床中与G-CSFR突变相关的疾病。该结论在原发性人CD34+脐血细胞中得到验证:相比正常细胞而言,表达突变G-CSFR的祖细胞能够表现出对药物依鲁替尼敏感性的增强,这也就证实了,利用依鲁替尼就能够消除G-CSFR突变的细胞,或能作为一种有效的疗法治疗患者。
详情请访问 肿瘤 http://www.kangantu.org/
















请简单描述您的疾病情况,我们会有专业的医学博士免费为您解答问题(24小时内进行电话回访)